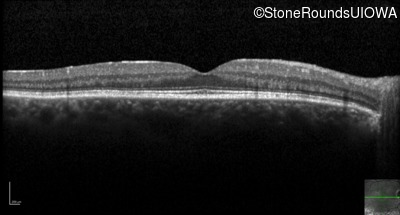
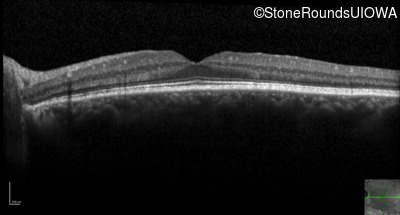
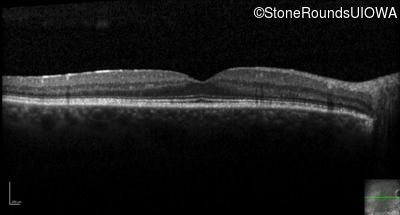
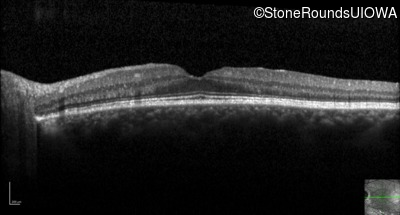

SR2091
AD Retinitis Pigmentosa (IA1aii)
Male
Male
SR2091
Student Mode
1AD Retinitis Pigmentosa (IA1aii)
2Male
Male
| Age at visit: 44 years |
Diagnosis & molecular findings
| Disease | Gene | Allele 1 variant(s) | Allele 2 variant(s) | Inheritance mode |
|---|---|---|---|---|
| AD Retinitis Pigmentosa | RHO | Val87Asp GTC>GAC | AD |